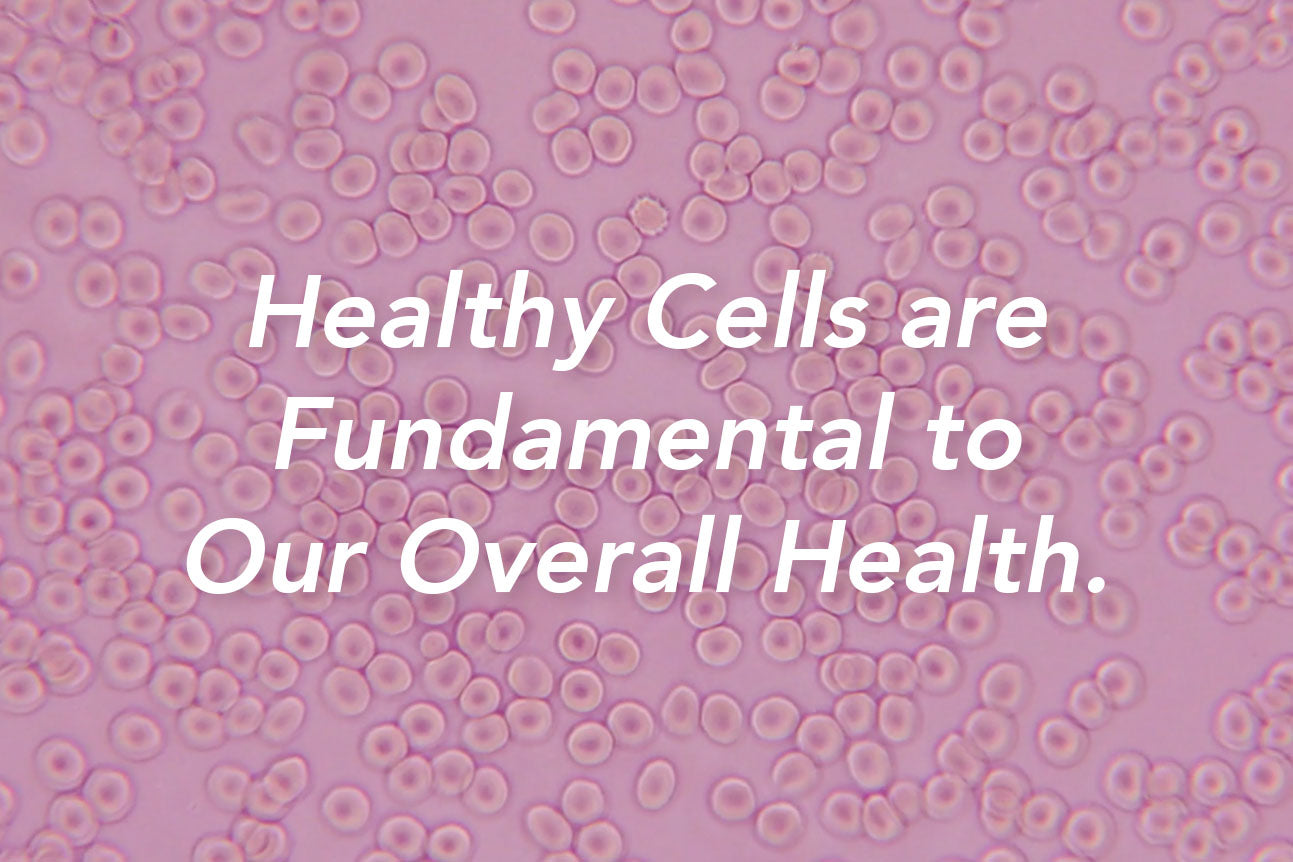

About
Vital Plan
Company and Vision

We Believe Wellness is Rooted in Nature
Our mission at Vital Plan is to make herbs and holistic living a simple, safe and effective part of everyone’s everyday, empowering people to regain good health and add full, vital years to their life. Backed by science and rooted in nature, we believe that vibrant health is available to everyone, no matter their current health status.
Founded and formulated by Bill Rawls, MD, we are dedicated to crafting premium, evidence-based supplements and remedies that harmonize with the body's intricate cellular system to promote lasting wellness.

Our Story
For 30 years, Dr. Rawls dedicated his life to medicine. When a mystery health crisis in his early forties abruptly changed his quality of life, he came face to face with the limitations of modern medicine and began to explore the vast possibilities of addressing the root causes of poor health.
After a lengthy search and countless visits to specialists he discovered that he had Lyme disease. This diagnosis and his ensuing journey through a variety of conventional and holistic approaches opened a door to better understanding of chronic illness in general, and led him to the one therapy that ended up being his ultimate salvation: herbal therapy.
Dr. Rawls’ path to better health through holistic and herbal therapies inspired him to share his revelations on wellness with the world. Alongside his daughter and CEO, Braden Rawls, Vital Plan was created to help people regain control of their health.

Science and Herb Expertise
During the quest to regain his health after Lyme disease, Dr. Rawls poured his soul into understanding the underlying causes of all chronic diseases and how to regain and maintain good health from a holistic viewpoint. His research led him to herbs and their effect on cellular health.
In his #1 bestselling book, The Cellular Wellness Solution: Tap Into Your Full Health Potential with the Science-Backed Power of Herbs, Dr. Rawls demonstrates why crucial natural phytochemicals from herbs are missing from our diet — and how they are the key to protecting cellular health, an essential component to living and aging well.
Through Vital Plan, Dr. Rawls and CEO Braden Rawls, offer the world an open door to better health with supplements created as a synergy of phytochemicals - products made with the highest quality ingredients, science-backed and proven to help you extend your years.
Learn More and Listen to Dr. Bill Rawls' Guest Appearances
Featured Podcasts
About Cellular Wellness
Vital Plan is a science-backed system of herbs and essential nutrients, proven to defend against cellular stress and promote lasting cellular health. Wellness starts at the cellular level, and yet today, cells are stressed like never before.
Although your body’s cells possess an incredible ability to regenerate and restore, the many pressures of modern life diminish this capacity, eroding your ability to stay healthy — especially as you age. Adopting the Vital Plan allows your cells to flourish with premium botanical extracts proven to optimize cellular resilience and create full-body harmony.

About the Company
Through a meticulous process, the Vital Plan team selects the very best manufacturing partners and ingredients of the highest quality in the world to formulate its supplement line to Dr. Rawls’ exact specifications. Together, the Vital Plan team develops potent custom blends that can not be found anywhere else.
In an era when almost every business claims to be socially and environmentally responsible, Vital Plan has gone the extra mile to validate these claims by being one of the earliest supplement companies to become a Certified B Corporation.® B Corps undergo independent verification to meet the highest standards of social and environmental performance, accountability, and transparency.
Who is Vital Plan for?
Vital plan is for anyone with cells. Yes, that’s you! Whether you are dedicated to maintaining health and vitality or looking for your path to regain wellness, Vital Plan can help you take back control of your health through cellular wellness and the untapped power of nature. Don’t know where to start? Take our Quiz or contact us to learn more.